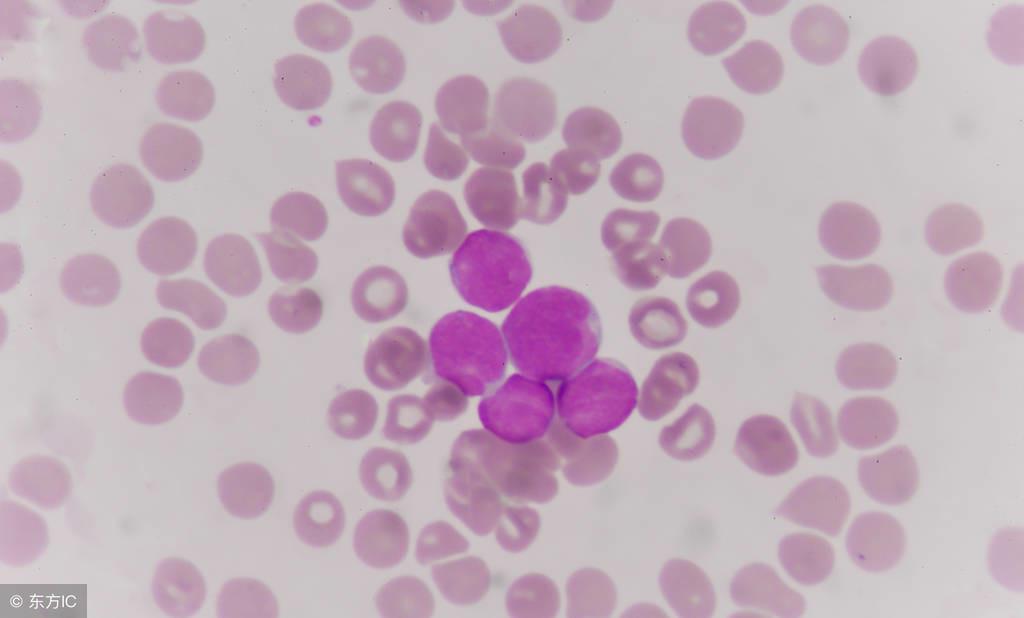
如果出现血小板减少如何用药调理,血小板减少可以输血补吗
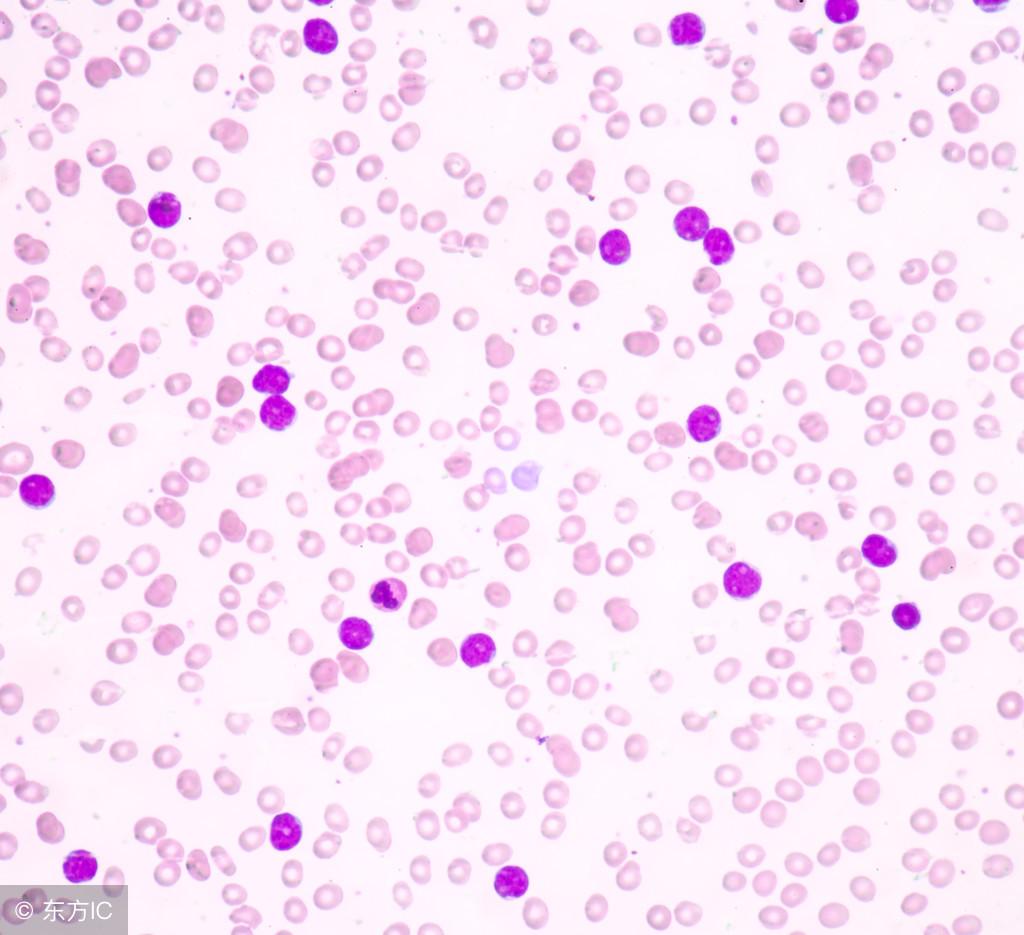
如果出现血小板减少如何用药调理,血小板减少可以输血补吗

很多人认为自己血液里面的成分是天生,只要不得什么大病是不会缺少的现象,其实这种想法是错的,当血小板减少就会出现症状的,那您知道血小板低的原因及后果是什么吗?您知道血小板减少的危害多大吗?血小板减少了,治疗就是让血小板增加,那就让治疗血液病医院带大家看看血小板减少吃什么好吧。

根据以上分析血热症状者饮食宜清凉之品,可以进食绿豆汤、兔肉、田螺、香蕉、甘蔗、橄榄、藕、冬瓜、丝瓜、空心菜、黄花菜、茭白等清解毒热之物。
气虚症状的血小板减少症患者饮食宜凉润之品,可以进食菠萝蜜、柿子、丝瓜、菠菜、空心菜、藕、蚌、银耳、木耳、*肉猫**、青鱼、黑鱼、鳖、干贝、河蟹、水龟肉、银鱼、鸭肉等滋阴凉血之物,以辅助治疗。
阴虚症状的血小板减少症患者饮食适宜,饮食宜甘温之物,可以进食牛肉、羊肉、鸽肉、海参、龙眼肉、蚕豆、栗子、大枣、南瓜、山药、甘薯、莲子、青梅等益气摄血之品。
血小板减少症患者在病情稳定期,应在饮食中多选用牛奶、鱼、瘦肉、豆制品等高蛋白食物。由于疾病的侵害使得患者机体对于蛋白质的消耗远高于普通人,蛋白质可以维持人体各器官组织的正常生命活动。
对于出现血小板减少症患者若出现紫癜伴贫血等症状后,在饮食中加入富含铁元素的食物,如动物肝脏、瘦肉、蛋黄、油菜、荠菜、圆白菜、番茄等对身体有益可以加快康复进程,减轻这些症状带给身体的痛苦。
当患者出血减少或停止时,饮食宜以健脾、益气、摄血为原则。此时应在饮食中选择红枣、花生衣等有升高血小板作用的食物制成菜肴。中医认为有“三红”可补血,红糖、红枣、红花生。多食用一些可以增加身体造血能力。